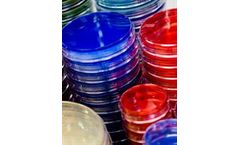
Dalynn - Model PA20 - Plated Media

- Home
- Equipment
Refine by
Dalynn Environmental Equipment & Supplies
7 equipment items found
Manufactured by:Dalynn Biologicals based inCalgary, ALBERTA (CANADA)
Acetone. Size 500 ...
Manufactured by:Dalynn Biologicals based inCalgary, ALBERTA (CANADA)
Our 0129 Disks are used for the differentiation of vibrios from other gram-negative bacteria. Shewan and Hodgkiss recognized the sensitivity of vibrios to the vibrio-static agent 0129 (2,4-diamino-6.7-di-isopropyl-pteridine phosphate) in 1954. 0129 was found to be useful in the differentiation of vibrios from other gram-negative bacteria especially aeromonads. which are characteristically ...
Manufactured by:Dalynn Biologicals based inCalgary, ALBERTA (CANADA)
EZ Test/B. stearothermophilus 10/5th. Size ...
Manufactured by:Dalynn Biologicals based inCalgary, ALBERTA (CANADA)
Acetylcysteine 100 mg / vial. Size ...
Manufactured by:Dalynn Biologicals based inCalgary, ALBERTA (CANADA)
Acinetobacter Agar Plate - 10 /package. Size ...
Manufactured by:Dalynn Biologicals based inCalgary, ALBERTA (CANADA)
Acanthamoeba Agar. Size ...
Manufactured by:Dalynn Biologicals based inCalgary, ALBERTA (CANADA)
Our Voges-Proskauer (VP) Reagents when used with MR-VP Broth can differentiate organisms based on their ability to produce the end product, acetylmethylcarbinol (acetoin). from glucose fermentation. This characteristic can be used to aid in the differentiation between ...